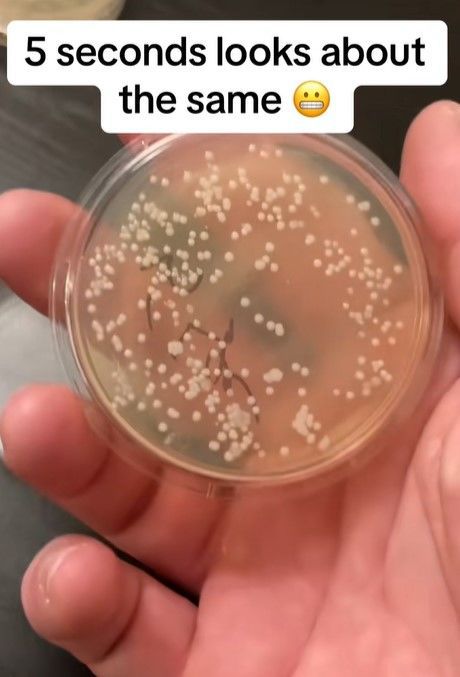
뉴시스

'0초 접시'에서도 박테리아 군집 득실
|
[서울=뉴시스] 미국 시카고 미생물학자 니콜라스 아이허는 5초 법칙을 증명하기 위한 실험을 진행했다.(사진=틱톡 갈무리) *재판매 및 DB 금지 |
[서울=뉴시스]홍주석 인턴 기자 = 음식물을 떨어트려 오염에 노출된 직후 5초 안에 주워 먹으면 안전하다고 믿는, 이른바 '5초 법칙'이 전 세계적으로 널리 알려져 있지만, 실제론 음식물이 바닥에 닿는 순간 박테리아가 증식할 수 있다는 실험 결과가 나왔다.
16일(현지시간) 영국 데일리메일에 따르면 미국 시카고 미생물학자 니콜라스 아이허는 자신의 사회관계망서비스(SNS) 틱톡에 '5초 법칙'을 증명하기 위해 물건을 바닥에 떨어트린 후 얼마나 많은 박테리아가 생기는지 확인하는 실험 영상을 올렸다.
아이허는 0초에서 1분까지 시간을 나눠 페트리 접시를 바닥에 놓고 그 접시를 인큐베이터에 넣고 배양해 박테리아가 자라는지 확인했다.
그 결과, 모든 접시에서 수백 개의 박테리아 군집이 관찰됐다.
그는 각각의 페트리 접시를 보여주면서 "떨어트린 직후 바로 줍는 것을 가정한 0초도 너무 길다. 5초든 60초든 (결과는) 충격적이다"라고 했다. 오염도는 시간과 무관하게 모두 높게 나타났다는 것.
해당 영상은 100만회가 넘는 조회 수를 기록하며, 큰 화제가 됐다.
영상을 접한 누리꾼들은 "결과가 충격적이다. 5초 법칙을 믿으며 살았는데, 이제는 그러지 않아야겠다" "다시는 바닥에 떨어진 음식을 먹지 않겠다" 등의 반응을 보였다.
반면, 일부 누리꾼들은 "5초 법칙에는 떨어진 음식을 인큐베이터에 넣고 배양하는 과정은 없다" "대조군이 있어야 하는데, 전부 바닥에 떨어트린 접시만 보여줬다" "지금껏 5초 법칙을 믿으며 건강하게 살아왔다" 등의 반응을 보였다.
앞서, 2016년 미국 럿거스대학교의 식품과학자 도널드 샤프너 교수는 연구를 통해 '음식이 바닥 등 박테리아로 덮인 표면 위에 오래 있을수록 더 많은 박테리아 군집이 달라붙지만, 음식이 표면에 닿자마자 이미 충분한 양의 박테리아 군집이 달라붙는다'는 사실을 발견한 바 있다.
☞공감언론 뉴시스 juseok@newsis.com
▶ 네이버에서 뉴시스 구독하기
▶ K-Artprice, 유명 미술작품 가격 공개
이 기사의 카테고리는 언론사의 분류를 따릅니다.
기사가 속한 카테고리는 언론사가 분류합니다.
언론사는 한 기사를 두 개 이상의 카테고리로 분류할 수 있습니다.
언론사는 한 기사를 두 개 이상의 카테고리로 분류할 수 있습니다.


